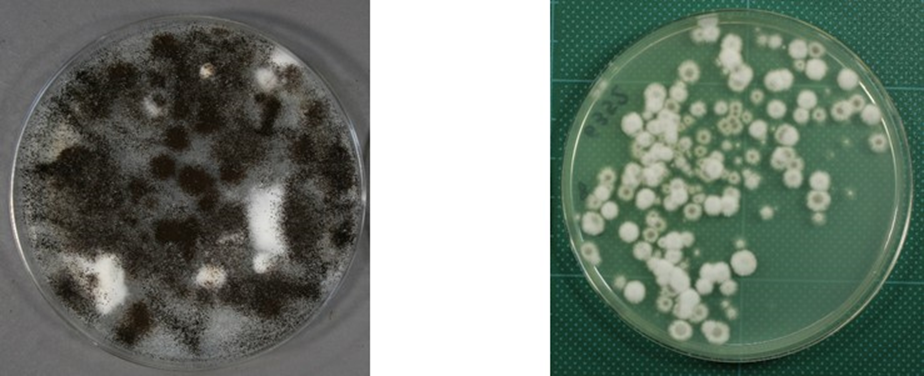
記事2画像1_メルマガ90号

NBRCニュース 第90号

今号の内容
1.
新たにご利用可能となった微生物株
酵母では沖縄県の花と土壌から分離された新種Yamadazyma thunbergiae(NBRC 116657, 116660)を公開しました。糸状菌では水圏環境や土壌に腐生菌として生息する他、植物に根腐れや茎腐れを引き起こすことが報告されているPhytopythiumやAphanomyces等の7菌株(NBRC 112855-112859, NBRC 114521, NBRC 114522)を公開しました。植物病害防除の研究に寄与することが期待されます。
【新たに分譲を開始した微生物資源】
https://www.nite.go.jp/nbrc/cultures/nbrc/new_strain/new_dna.html
2.
微生物あれこれ(64)
変幻自在なカビの世界
~Aspergillus属、Penicillium属菌の多様なコロニー形態~
(森谷 千星)
一般的にカビと称される糸状菌は、培養条件によって多様なコロニーを形成します。培地、温度、菌体密度などの違いが、色、形、質感に影響を与えるため、同じ菌株でも見た目が異なるコロニーが現れることがあります。今回は、よくお問い合わせを頂くAspergillus属、Penicillium属の菌株のコロニーの違いについて、いくつかの例をご紹介いたします。
【例1】有色のコロニーの中に白いコロニーが出現・・・!?
Aspergillus属やPenicillium属菌は、黄色や黒、赤、青、緑といった色の胞子を形成する種が多いのですが、時折、白色のコロニーが現れることがあります。これは、色の付いた胞子を形成せずに、菌糸のみで生育している時に見られる現象です。継代を繰り返すことで、胞子形成能が低下することがあり、こうした変化が原因となります。また、コロニーごとに胞子の色のつき方や、胞子と白色の菌糸の割合が異なることで、濃淡による色調の違いが見られることもあります。
【例1】有色のコロニーの中に白いコロニーが出現・・・!?
Aspergillus属やPenicillium属菌は、黄色や黒、赤、青、緑といった色の胞子を形成する種が多いのですが、時折、白色のコロニーが現れることがあります。これは、色の付いた胞子を形成せずに、菌糸のみで生育している時に見られる現象です。継代を繰り返すことで、胞子形成能が低下することがあり、こうした変化が原因となります。また、コロニーごとに胞子の色のつき方や、胞子と白色の菌糸の割合が異なることで、濃淡による色調の違いが見られることもあります。
【例2】複数の色や形態のコロニーが出現・・・!?
菌種によっては性質上、複数の色や形態のコロニーを形成することがあります。例えば、Penicillium islandicum NBRC 7601は緑やオレンジなど様々な色のコロニーを形成します。この種はアントラキノン系やスカイリン系の色素を産生(1)することが知られており、多彩な色を示しますが、見た目がこれだけ異なっても、同じ菌株です。

一方、Aspergillus tonophilus NBRC 8157Tは黄色や緑のコロニーを形成しますが、こちらは胞子の種類※に起因します。黄色は有性生殖によって生じる閉子嚢殻(子嚢胞子の包まれた袋状の壁)を旺盛に形成しているコロニーで、緑色は無性生殖によって生じる分生子を旺盛に形成しているコロニーになります。そのため、これだけ異なった見た目ではありますが、同じ菌株です。
NBRCでは、品質管理の過程で確認された各菌株のコロニーの画像情報を、DBRP(生物資源データプラットフォーム)の各菌株情報ページに掲載しております。ぜひご活用ください。
DBRP:https://www.nite.go.jp/nbrc/dbrp/top
◆コロニー形状に関するトラブルシューティング◆
同一の菌株なのか異なる菌株なのか判断がつかない
見た目の異なるコロニーをそれぞれ柄付き針などで釣菌して培養し、Aspergillus属菌についてはカルモジュリン遺伝子、Penicillium属菌についてはカルモジュリンやβ-チューブリン遺伝子など、その菌種を同定できる遺伝子塩基配列の取得を行い、各コロニーの配列が一致するか確認することをおすすめいたします。
胞子形成能を維持したい
できる限り継代培養を避けることをおすすめします。胞子形成の旺盛な有色のコロニーから複数の凍結保存標品を作製します。復元に使用した標品は使い切り、再凍結して保存することは避けてください。
【一般的な糸状菌の凍結保存方法】
https://www.nite.go.jp/nbrc/cultures/others/nbrcnews/news_vol03.html#news3_2
【復元方法】
https://www.nite.go.jp/nbrc/cultures/support/ampoule.html
【継代数の数え方とシードロットシステム】
https://www.nite.go.jp/nbrc/cultures/others/nbrcnews/news_vol23.html#news23_3
胞子形成を旺盛にしたい(なるべく白いコロニーを少なく培養したい)
胞子形成には通気性をよくすることが重要であるため、Aspergillus属やPenicillium属菌を平板培地(シャーレ)で培養する場合は、植菌後のシャーレにパラフィルム等は巻かず培養してください。
【参考】https://www.nite.go.jp/nbrc/cultures/others/nbrcnews/news_vol62.html#news62_2
※ 菌類では分類群及び生殖様式によって胞子の名称が異なります。Aspergillus属、Penicillium属菌が属する子嚢菌門では有性生殖で生じた胞子は子嚢胞子と呼ばれ、無性生殖で生じた胞子は分生子と呼ばれます。
DBRP:https://www.nite.go.jp/nbrc/dbrp/top
◆コロニー形状に関するトラブルシューティング◆
同一の菌株なのか異なる菌株なのか判断がつかない
見た目の異なるコロニーをそれぞれ柄付き針などで釣菌して培養し、Aspergillus属菌についてはカルモジュリン遺伝子、Penicillium属菌についてはカルモジュリンやβ-チューブリン遺伝子など、その菌種を同定できる遺伝子塩基配列の取得を行い、各コロニーの配列が一致するか確認することをおすすめいたします。
胞子形成能を維持したい
できる限り継代培養を避けることをおすすめします。胞子形成の旺盛な有色のコロニーから複数の凍結保存標品を作製します。復元に使用した標品は使い切り、再凍結して保存することは避けてください。
【一般的な糸状菌の凍結保存方法】
https://www.nite.go.jp/nbrc/cultures/others/nbrcnews/news_vol03.html#news3_2
【復元方法】
https://www.nite.go.jp/nbrc/cultures/support/ampoule.html
【継代数の数え方とシードロットシステム】
https://www.nite.go.jp/nbrc/cultures/others/nbrcnews/news_vol23.html#news23_3
胞子形成を旺盛にしたい(なるべく白いコロニーを少なく培養したい)
胞子形成には通気性をよくすることが重要であるため、Aspergillus属やPenicillium属菌を平板培地(シャーレ)で培養する場合は、植菌後のシャーレにパラフィルム等は巻かず培養してください。
【参考】https://www.nite.go.jp/nbrc/cultures/others/nbrcnews/news_vol62.html#news62_2
※ 菌類では分類群及び生殖様式によって胞子の名称が異なります。Aspergillus属、Penicillium属菌が属する子嚢菌門では有性生殖で生じた胞子は子嚢胞子と呼ばれ、無性生殖で生じた胞子は分生子と呼ばれます。
3.
びせいぶつ学習帳:知っているようで知らない微生物の話(2)
私たちの生活を支える微生物:知られざるカビとキノコの違い
(永田 航也)
■カビとキノコ、あなたはどっち派?
カビマニア(NBRCにはよくいる)でなければ、多くの方はキノコの方に良いイメージを持っているのではないでしょうか。カビはお風呂場やエアコンに生えたり、ミカンやお餅などの食品を腐らせたりする厄介者というイメージがある一方で、キノコは重要な食材であるだけでなく、その愛らしい形から某有名ゲームのキャラクターやアイテムのモチーフとして使用され、生活を彩る存在として人気があります。
■カビとキノコ、分類学的には同じ生き物?
このように一般的なイメージは大きく異なりますが、キノコはカビの仲間だということをご存じですか。学術的には、カビとキノコは共に「菌類」に属しています。では、カビとキノコの違いとは何でしょうか?ざっくり言うと、子実体(しじつたい)と呼ばれるいわゆる「きのこ」を作るか、作らないかの「見た目」の違いだけです。
• カビ:糸状の構造をした菌糸で生活することから「糸状菌」とも呼ばれます。菌糸が少ないうちは肉眼ではほとんど見ることができないですが、菌糸が成長して広がるとお風呂場の黒いシミのように肉眼で見ることができるようになります。
• キノコ:菌糸が集まってできた子実体と呼ばれる大型の構造を作ります。このため大型菌類と呼ばれます。面白いことに、キノコを培地(微生物が成育するために必要な栄養を寒天で固めたもの)で培養すると糸状の構造をしたカビの姿になります。
【例】ウシグソヒトヨタケ(NBRC 30116)
カビマニア(NBRCにはよくいる)でなければ、多くの方はキノコの方に良いイメージを持っているのではないでしょうか。カビはお風呂場やエアコンに生えたり、ミカンやお餅などの食品を腐らせたりする厄介者というイメージがある一方で、キノコは重要な食材であるだけでなく、その愛らしい形から某有名ゲームのキャラクターやアイテムのモチーフとして使用され、生活を彩る存在として人気があります。
■カビとキノコ、分類学的には同じ生き物?
このように一般的なイメージは大きく異なりますが、キノコはカビの仲間だということをご存じですか。学術的には、カビとキノコは共に「菌類」に属しています。では、カビとキノコの違いとは何でしょうか?ざっくり言うと、子実体(しじつたい)と呼ばれるいわゆる「きのこ」を作るか、作らないかの「見た目」の違いだけです。
• カビ:糸状の構造をした菌糸で生活することから「糸状菌」とも呼ばれます。菌糸が少ないうちは肉眼ではほとんど見ることができないですが、菌糸が成長して広がるとお風呂場の黒いシミのように肉眼で見ることができるようになります。
• キノコ:菌糸が集まってできた子実体と呼ばれる大型の構造を作ります。このため大型菌類と呼ばれます。面白いことに、キノコを培地(微生物が成育するために必要な栄養を寒天で固めたもの)で培養すると糸状の構造をしたカビの姿になります。
【例】ウシグソヒトヨタケ(NBRC 30116)

(左)キノコの姿をしたウシグソヒトヨタケ (右)カビの姿をしたウシグソヒトヨタケ
【ウシグソヒトヨタケのきのこ(子実体)形成(動画)】
https://youtu.be/lwzhzFBi2-4?list=PLWxWKUOj3xALDWKbO5dZKbDrt3ZLO7DWn
■カビとキノコ、どちらも私たちのくらしに欠かせないもの
カビには「悪いイメージ」がつきまといますが、実は私たちの生活にとって非常に重要な存在です。例えばカビは、食品や医薬品の分野で大活躍しています。味噌や醤油などの栄養豊富な発酵食品は、カビの力なしには作れません。また、カビから得られる成分は医薬品の開発にも寄与しています。特にペニシリンは青カビから発見された抗生物質で、多くの感染症治療に革命をもたらしました。
さらに、実は農業の分野でも広く活用されていることをご存知でしょうか。よく知られた話では、植物と共生するアーバスキュラー菌根菌は、共生している植物に土壌の養分を供給するため、環境負荷の低いバイオ肥料として使用されています。
https://youtu.be/lwzhzFBi2-4?list=PLWxWKUOj3xALDWKbO5dZKbDrt3ZLO7DWn
■カビとキノコ、どちらも私たちのくらしに欠かせないもの
カビには「悪いイメージ」がつきまといますが、実は私たちの生活にとって非常に重要な存在です。例えばカビは、食品や医薬品の分野で大活躍しています。味噌や醤油などの栄養豊富な発酵食品は、カビの力なしには作れません。また、カビから得られる成分は医薬品の開発にも寄与しています。特にペニシリンは青カビから発見された抗生物質で、多くの感染症治療に革命をもたらしました。
さらに、実は農業の分野でも広く活用されていることをご存知でしょうか。よく知られた話では、植物と共生するアーバスキュラー菌根菌は、共生している植物に土壌の養分を供給するため、環境負荷の低いバイオ肥料として使用されています。
また、Akanthomyces muscarium などのカビは、農業で深刻な問題を引き起こす植物病原菌に寄生し、その活動を抑制することから、生物農薬としての活用が検討されています。このように、カビは環境に優しい循環型農業の実現に貢献することが期待されています。一方、キノコは私たちの食卓には欠かせないことから、食材のイメージが強いのではないでしょうか。近年ではさらに、環境負荷の低減に繋がるとの観点で「Mycotech(マイコテック)」と呼ばれるキノコ・カビを利用した代替肉(マイコプロテイン)、革の代替となる素材、生分解性の梱包材や建材(レンガ)などの開発が期待されています。
以上のように、カビやキノコは多くの可能性を秘めた微生物であると言えます。
前回の「菌未来:キノコが拓く新たなバイオ産業革命」においても、Mycotechについて紹介しておりますので、併せてご覧いただけますと幸いです。
■さいごに
菌類の魅力を伝えたいあまり長々と語ってしまいましたが、つまり、カビとキノコは印象が大きく異なるものの、実際には「見た目」が違うだけでどちらも同じ菌類に分類され、私たちのくらしに欠かせない素晴らしい微生物であるということです。ぜひこの機会に、キノコだけでなく、カビも好きになってください!
NBRCは、カビ・キノコを含め、多種多様な微生物を9.5万株以上保有し、産業界や大学に提供することで、日本の産業を支えています。まだまだ謎の多いカビとキノコの可能性を共に開拓し、彼らの力を活用していきましょう!
4.
DBRP(生物資源データプラットフォーム)
~国内由来RD株の情報更新のお知らせ~
国内由来RD株のデータを更新しました(2024年9月24日)。今回更新した株の中には、2024年5月に提供を開始した酒まんじゅう酛から分離した酵母6株と乳酸菌8株や、2024年4月に提供を開始した生乳から分離した乳酸菌18属146株とビフィドバクテリウム属1株(RD株リスト中の生物区分では乳酸菌に含まれます)、その他に好気性細菌5属26株が含まれ、合計187株の情報追加を行いました。
国内由来RD株は、新製品開発のためのスクリーニング材料としてご利用いただけるように、NBRC株より安価に提供しています。実際にRD株を活用した事例はNBRCニュースでご紹介しております(株式会社東洋発酵、和歌山県工業技術センター)。RD株はリボソームRNA遺伝子塩基配列解析の結果から、分類学的に新規と推定される多数の微生物が含まれており、新しい機能を秘めているかもしれません。ぜひご活用ください。
【今回更新された国内由来RD株ページ】
https://www.nite.go.jp/nbrc/dbrp/releasedatalist?releaseId=20240924_2024RD
【国内由来RD株コレクションページ】
https://www.nite.go.jp/nbrc/dbrp/dataview?dataId=COLL0000000000002
【国内由来RD株の利用手続き】
https://www.nite.go.jp/nbrc/cultures/rd/appli_new_j.html
国内由来RD株は、新製品開発のためのスクリーニング材料としてご利用いただけるように、NBRC株より安価に提供しています。実際にRD株を活用した事例はNBRCニュースでご紹介しております(株式会社東洋発酵、和歌山県工業技術センター)。RD株はリボソームRNA遺伝子塩基配列解析の結果から、分類学的に新規と推定される多数の微生物が含まれており、新しい機能を秘めているかもしれません。ぜひご活用ください。
【今回更新された国内由来RD株ページ】
https://www.nite.go.jp/nbrc/dbrp/releasedatalist?releaseId=20240924_2024RD
【国内由来RD株コレクションページ】
https://www.nite.go.jp/nbrc/dbrp/dataview?dataId=COLL0000000000002
【国内由来RD株の利用手続き】
https://www.nite.go.jp/nbrc/cultures/rd/appli_new_j.html
5.
cereco利用規約改定のお知らせ
cereco(セレコ)は、質量分析計によるセレウス菌グループの簡便な同定を支援するツールと、既知のセレウス菌に関連する情報等を収集・整理し提供するシステムで、2023年7月からサービスを開始しています。
2024年9月にcerecoの利用規約を改定いたしました。これまで、cerecoの用途を自社製品の品質管理の範囲内に限定していましたが、関連特許の開放に伴い、この制限を解除しました。商業利用も可能となり、より幅広くcerecoをご利用いただけるようになりましたので、是非ご活用ください。
cerecoの利用にはアカウントが必要です。アカウントについては、以下URLをご参照ください。
cereco利用の案内:https://www.nite.go.jp/nbrc/genome/db/cereco.html
2024年9月にcerecoの利用規約を改定いたしました。これまで、cerecoの用途を自社製品の品質管理の範囲内に限定していましたが、関連特許の開放に伴い、この制限を解除しました。商業利用も可能となり、より幅広くcerecoをご利用いただけるようになりましたので、是非ご活用ください。
cerecoの利用にはアカウントが必要です。アカウントについては、以下URLをご参照ください。
cereco利用の案内:https://www.nite.go.jp/nbrc/genome/db/cereco.html
編集後記
前回から始まった新コンテンツ「びせいぶつ学習帳」は、微生物マニアになっていないNBRC若手職員がそれぞれの切り口で、微生物の情報を伝える企画です。前回に引き続き、今回のびせいぶつ学習帳では、カビとキノコの魅力についてご紹介いたしました。
「電車で行く、キノコ狩りツアー(お土産2 kg付き)」→「電車で行く、カビ狩りツアー(お土産2 kg付き)」、「キノコたっぷりの鍋」→「カビたっぷりの鍋」、「カビの生えたエアコン」→「キノコの生えたエアコン」などなど・・・。
(NBRC5年目の私も染まりつつあるのか、気づきませんでしたが、、笑)確かにカビとキノコで印象は違いますね(KM)
前回から始まった新コンテンツ「びせいぶつ学習帳」は、微生物マニアになっていないNBRC若手職員がそれぞれの切り口で、微生物の情報を伝える企画です。前回に引き続き、今回のびせいぶつ学習帳では、カビとキノコの魅力についてご紹介いたしました。
「電車で行く、キノコ狩りツアー(お土産2 kg付き)」→「電車で行く、カビ狩りツアー(お土産2 kg付き)」、「キノコたっぷりの鍋」→「カビたっぷりの鍋」、「カビの生えたエアコン」→「キノコの生えたエアコン」などなど・・・。
(NBRC5年目の私も染まりつつあるのか、気づきませんでしたが、、笑)確かにカビとキノコで印象は違いますね(KM)
・画像付きのバックナンバーを以下のサイトに掲載しております。受信アドレス変更、受信停止も以下のサイトからお手続きいただけます。
NBRCニュースバックナンバー
・NBRCニュースは配信登録いただいたメールアドレスにお送りしております。万が一間違えて配信されておりましたら、お手数ですが、以下のアドレスにご連絡ください。
・ご質問、転載のご要望など、NBRCニュースについてのお問い合わせは、以下のアドレスにご連絡ください。
・掲載内容を許可なく複製・転載することを禁止します。
・NBRCニュースは偶数月の1日(休日の場合はその前後)に配信します。次号(第91号)は2025年2月3日に配信予定です。
編集・発行
独立行政法人製品評価技術基盤機構(NITE)バイオテクノロジーセンター(NBRC)
NBRCニュース編集局(nbrcnews【@】nite.go.jp)
(メールを送信される際は@前後の【】を取ってご利用ください)
NBRCニュースバックナンバー
・NBRCニュースは配信登録いただいたメールアドレスにお送りしております。万が一間違えて配信されておりましたら、お手数ですが、以下のアドレスにご連絡ください。
・ご質問、転載のご要望など、NBRCニュースについてのお問い合わせは、以下のアドレスにご連絡ください。
・掲載内容を許可なく複製・転載することを禁止します。
・NBRCニュースは偶数月の1日(休日の場合はその前後)に配信します。次号(第91号)は2025年2月3日に配信予定です。
編集・発行
独立行政法人製品評価技術基盤機構(NITE)バイオテクノロジーセンター(NBRC)
NBRCニュース編集局(nbrcnews【@】nite.go.jp)
(メールを送信される際は@前後の【】を取ってご利用ください)
お問い合わせ
-
独立行政法人製品評価技術基盤機構 バイオテクノロジーセンター
生物資源利用促進課
(お問い合わせはできる限りお問い合わせフォームにてお願いします) -
TEL:0438-20-5763
住所:〒292-0818 千葉県木更津市かずさ鎌足2-5-8 地図
お問い合わせフォームへ















